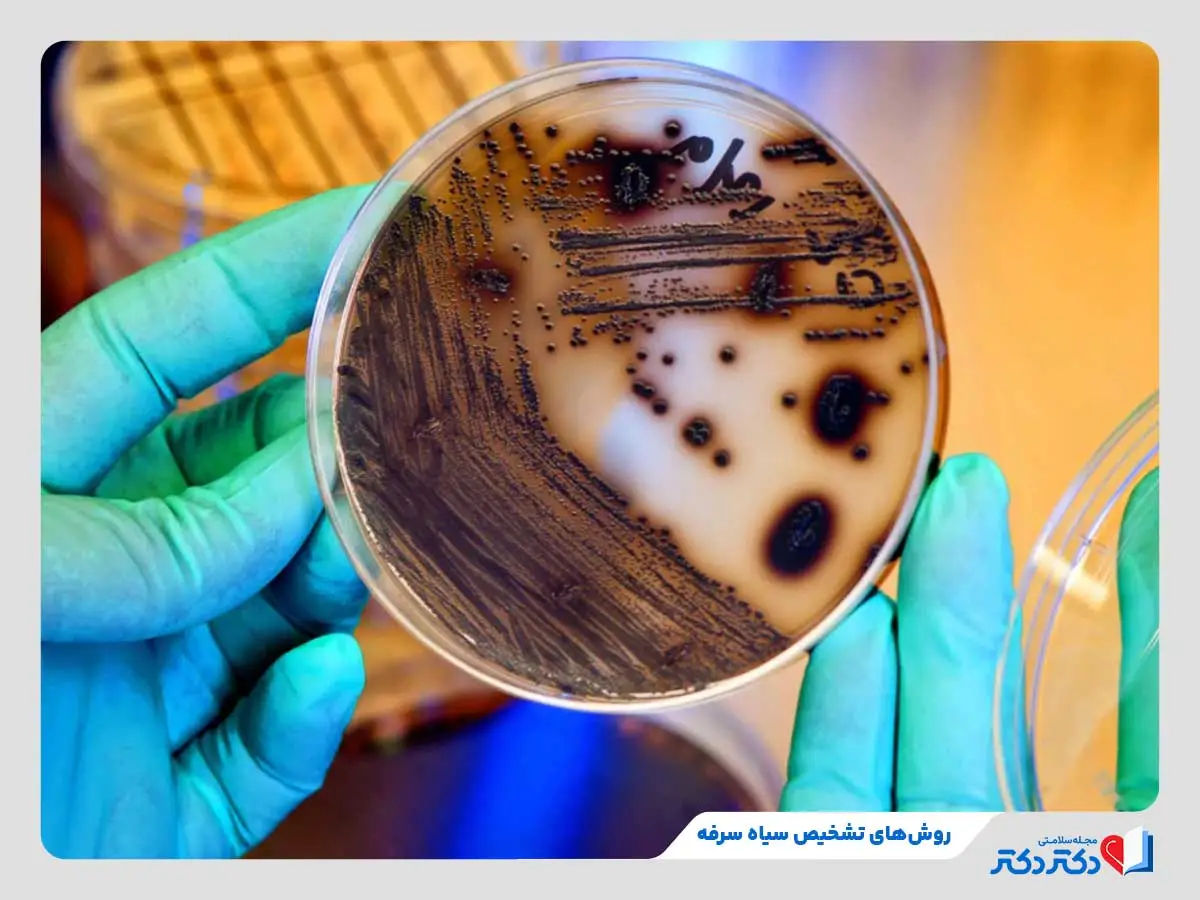
سیاه سرفه چیست؟ + علائم و درمان آن در کودکان و بزرگسالان_رنگو 26 تست PCR برای تشخیص نوع باکتری عامل ایجاد سیاه سرفه

[ad_1]
نوشته و ویرایش شده توسط مجله ی رنگو
بیماری عفونی و تنفسی که از طریق باکتری بوردتلا پرتوسیس تشکیل میبشود را سیاه سرفه میگویند. این بیماری زیاد واگیردار است و بهاختصاصی در نوزادان و کودکان نیاز به مراجعه سریع به پزشک متخصص دارد. واکسن سیاه سرفه یک روش موثر برای پیشگیری از این بیماری است. تزریق این واکسن بهاختصاصی در کودکان و نوزادان اثربخشی بیشتری دارد. علائم سیاه سرفه شامل سرفههای شدید و مکرر، تب، آبریزش بینی و کبود شدن صورت زمان سرفه میبشود. این علائم سپس از دوره نهفتگی بیماری در فرد ظاهر خواهد شد، به همین علت در مرحله های اولیه، دکتر ریه نیاز به تجویز تستهای گوناگون برای تشخیص آن دارد. سپس از تشخیص نیز، درمان سیاه سرفه با منفعت گیری از آنتیبیوتیکها میتواند علتاز بین رفتن عفونت و بهمرور بهبود بیماری بشود.
برای آشنایی با بیماری سیاه سرفه، علائم و درمان آن در کودکان و بزرگسالان، تا انتهای این نوشته از مجله سلامت و پزشکی دکتردکتر با ما همراه باشید.
هماین چنین، میتوانید سوال خود را در قسمت کامنتها سوال کنید، تا کارشناس سلامتی دکتردکتر جواب دهد.
سیاه سرفه چیست؟
سیاه سرفه، یک بیماری عفونی تنفسی است که توسط باکتری بوردتلا پرتوسیس تشکیل میبشود. علائم سیاه سرفه شامل حملات شدید و پیدرپی سرفه است. این بیماری بهشدت مسری، زیاد تر از طریق تنفس و ترشحات بینی و حلق منتقل میبشود. اگرچه واکسیناسیون بهطور قابلتوجهی شیوع این بیماری را افت داده است، اما همچنان میتواند خطرناک باشد.واکسیناسیون بهطور قابلتوجهی علتکاهش شیوع این بیماری شده است، اما همچنان میتواند خطرناک باشد. تهدید این بیماری در نوزادان و کودکان خردسال جدیتر است. سیاه سرفه میتواند تبدیل مشکلات تنفسی شدید، خستگی مفرط و در موارد نادر، مرگ بشود. دوره نهفتگی این بیماری بین ۸ تا ۱۴ روز است و از ۲ هفته قبل از اغاز دعواهای سرفه تا نزدیک به ۲ ماه نیز امکان انتقال آن وجود دارد.

به نقل از CDC، وبسایت رسمی دولت ایالات متحده:
بوردتلا پرتوسیس، باکتری عامل سیاه سرفه، مدام در سطح ژنتیکی تحول میکند. بههمینعلت، همچنان نیاز به برسی این نوشته است که تغییرات مولکولی در ساختار این باکتری، درصورتوجود، چه اثری بر سلامت عمومی دارند.
آیا سیاه سرفه خطرناک است و میتواند علتمرگ بشود؟
سیاه سرفه طبق معمول از طریق هوا و با سرفه یا عطسه افراد آلوده قابل انتقال است. سیاه سرفه نوزادان و کودکان میتواند علائمی همانند سرفه کودکان از نوع شدید را به جستوجو داشته باشد. شدت سرفهها بعضی اوقات اینقدر شدید است که علتسیاه شدن صورت کودک میبشود. به این علت اگر فردی به خصوص کودکان و نوزادان به سیاه سرفه مبتلا شدند باید سریع به پزشک متخصص مراجعه کنید. با اهمیت ترین علل خطرناک بودن سیاه سرفه به سه عامل زیر بستگی دارد:
- عوارض جدی؛ سیاه سرفه میتواند عوارضی همانند عفونتهای ریوی، صدمه به دندهها، تشنج و در موارد شدید، حتی مرگ را به جستوجو داشته باشد.
- خطر برای نوزادان؛ نوزادان به علت سیستم ایمنی ضعیفتر، بیشتر در معرض خطر عوارض شدید و مرگ ناشی از سیاه سرفه قرار دارند.
- انتقال آسان؛ این بیماری زیاد مسری است و بهشدت در بین افراد، بهاختصاصی در محیطهایی عمومی گسترش اشکار میکند.
- افت تاثییر ایمنی با گذشت زمان؛ ایمنی ایجادشده توسط واکسن سیاه سرفه امکان پذیر با گذشت زمان افت اشکار کند. به این علت، افراد بزرگسال نیز در معرض خطر ابتلا به این بیماری قرار دارند.
افراد بزرگسال با ابتلا به سیاه سرفه طبق معمول بدون بستری شدن در بیمارستان و تنها با دریافت دارو و استراحت کافی، بهبود اشکار میکنند. اما در رابطه با کودکان و نوزادان، این بیماری خطرناک است و در کودکان زیر یک سال طبق معمول تبدیل بستری شدن در بیمارستان میبشود.

سیاه سرفه کودکان چه علائمی دارد؟
همان گونه که گفتیم، سیاه سرفه در کودکان میتواند زیاد خطرناک باشد. خبر از علائم سیاه سرفه کودکان میتواند در پیگیری روال درمان و طی کردن سریع تر دوره نقاهت آن زیاد موثر باشد.
| علائم سیاه سرفه کودکان | بعضی اوقات، آبریزش بینی بدون سرماخوردگی میتواند از علائم سیاه سرفه باشد. |
| کیپ شدن بینی | |
| آبریزش بینی | |
| قرمزی چشم | |
| تب | |
| سرفه شدید و طویل | |
| در برخی موارد، ترشحات مخاط بینی و دهان | |
| کبود شدن صورت زمان سرفهکردن |
علائم سیاه سرفه ابتدا به طور خفیف ابراز اشکار میکند و سپس از گذشت یک تا دو هفته تشدید میبشود. دراینحالت، تجمع موکوس در مجاری تنفسی علتسخت شدن فرایند نفس کشیدن خواهد شد. درنتیجه، سرفه کردن با شدت بیشتری ادامه اشکار میکند. این سرفهها و بهعبارت بهتر حملات سرفهای، میتوانند علتابراز علائم زیر در بیمار شوند:
- استفراغ
- صورت کبود یا قرمز
- خستگی شدید
- خونریزی بینی
- خفگی یا آپنه خواب
- تشکیل صدای سوت زمان نفس گرفتن بین سرفهها
عفونت باکتریایی عامل تشکیل سیاه سرفه کودکان میتواند علتابراز خطرات جدی برای سلامتی بشود. به این علت، بهمحض ابراز علائم، حتما باید به دکتر کودکان مراجعه کنید. تشخیص بهموقع این بیماری توسط دکتر اطفال، در جلوگیری از تشدید علائم و عفونت زیاد موثر است.
آیا علائم سیاه سرفه بزرگسالان با کودکان متفاوت است؟
علائم سیاه سرفه بزرگسالان نیز شبیه کودکان است. این علائم طبق معمول در کودکان با شدت بیشتری ظاهر میبشود و در برخی موارد میتواند علتبستری شدن در بیمارستان بشود. سیاه سرفه در بارداری میتواند علتتشدید مشکلات تنفسی و در برخی موارد ابراز عوارض جدی در مادر بشود. هنگامیکه مادر در دوران بارداری به سیاه سرفه مبتلا میبشود، امکان پذیر این بیماری به جنین نیز انتقال اشکار کند.
بیماری سیاه سرفه چطور منتقل میبشود؟
سیاه سرفه طبق معمول از طریق هوا و به راه حلهای زیر از فردی به فرد دیگر انتقال اشکار میکند:
- تنفس؛ زمان سرفه یا عطسه افراد مبتلا، قطرات زیاد ریزی حاوی باکتری بیماری سیاه سرفه در هوا انتشار میبشود.
- استنشاق قطرات آلوده؛ افرادی که در مجاورت فرد بیمار قرار دارند با استنشاق این قطرات آلوده، به سیاه سرفه مبتلا خواهد شد.
- تماس مستقیم با ترشحات بینی و گلو؛ تماس مستقیم با ترشحات بینی و گلو فرد آلوده نیز میتواند تبدیل انتقال این بیماری بشود.
به این علت در یک جمله و بهطورخلاصه میتوان او گفت: سیاه سرفه از طریق هوا و بهخصوص زمان سرفه یا عطسه فرد بیمار به افراد دیگر منتقل میبشود.

چرا به سیاه سرفه مبتلا میشویم؟
علت ابتلا به سیاه سرفه، باکتری بوردتلا پرتوسیس است. این باکتری با دعوا به دستگاه تنفسی، علتسرفههای شدید و طویل میبشود که بعضی اوقات اوقات میتواند به قدری شدید باشد که تبدیل کبودی صورت بشود. اگرچه سیاه سرفه بیشتر در کودکان شیوع دارد، اما بزرگسالان نیز میتوانند به این بیماری مبتلا شوند. این بیماری به شدت مسری است و از طریق هوا، بهخصوص زمان سرفه یا عطسه، از فرد بیمار به دیگران منتقل میبشود.
راه حلهای تشخیص سیاه سرفه کدام است؟
یکی از مشکلات مهم در بیماری سیاه سرفه، این است که موقع ابراز، علائمی همانند سرماخوردگی یا آنفولانزا دارد. این علائم به مرور تشدید خواهد شد و تشخیص بیماری را آسانتر میکنند. تنها روش تشخیص سیاه سرفه در روزهای اول ابتلا، انجام تستهای آزمایشگاهی مخصوص است. ازجمله این راه حلهای تشخیصی میتوان به موارد زیر اشاره کرد:
- کشت باکتریایی؛ این روش، به تشخیص باکتری و آنتیبیوتیک موثر برای درمان آن پشتیبانی میکند.
- عکس العمل زنجیرهای پلیمراز یا PCR؛ پیسیآر نیز در تشخیص نوع باکتری عامل تشکیل عفونت موثر است.
- تست سرولوژی؛ در این تست با منفعت گیری از آنتیبادی، بیماری را تشخیص خواهند داد.
تشخیص سیاه سرفه در تخصص دکتر ریه است. فوقتخصص ریه با بازدید علائم و تجویز تستهای ملزوم این کار را انجام میدهد. زمان مراجعه به پزشک میتوانید برای یافتن جواب سوال تخصص ریه چیست نیز از او مشاوره بگیرید. هماین چنین، متخصص ریه با دانش و توانایی خود میتواند در رابطه انواع بیماریهای ریه، راه حلهای تشخیص و درمان آنها، اطلاعات ملزوم را در اختیار شما قرار دهد.
ابتلا به سیاه سرفه چه عوارضی دارد؟
افراد بزرگسال درصورت ابتلا به سیاه سرفه طبق معمول با استراحت و دارو بهبود اشکار می کنند و کمتر دچار مشکل جدی می شوند. اما بعضی اوقات اوقات، امکان پذیر شدت بیماری زیاد باشد و علتابراز عوارض زیر بشود:
- کبودی یا شکستن دندهها
- فتق شکمی
- پاره شدن رگ های خونی دست یا چشم
اما این عوارض در کودکان و نوزادان با شدت بیشتری ظاهر میبشود. ازجمله عوارض سیاه سرفه در نوزادان زیر ۶ ماه میتوان به موارد زیر اشاره کرد:
- ذات الریه
- تشنج
- صدمه مغزی
- مشکلات تغذیه ای و افت وزن
- کمآبی بدن
- کندی یا توقف تنفس
- برونشکتازی ریه
یکی از با اهمیت ترین عوارض سیاه سرفه مرگ نوزادان است. این قضیه بهخصوص در نوزادان زیر ۶ ماه اهمیت بالاتری دارد.
چطور میتوان سیاه سرفه را درمان کرد؟
درمان سیاه سرفه با دقت به سن بیمار انجام میبشود. درصورتیکه طول زمان نهفتگی این بیماری در بدن بیمار بیشتر از ۳ هفته باشد، دارویی تجویز نمیبشود. علت این است که دوره زندگی باکتری این بیماری در این زمان همه شده است. درصورت نیاز به درمان، راه حلهای گوناگون آن شامل موارد زیر خواهد شد:
مصرف آنتیبیوتیک برای درمان سیاه سرفه
با تشخیص سیاه سرفه، بلافاصله درمان با آنتیبیوتیک اغاز میبشود. آنتیبیوتیکهای زیر بیشترین مورد منفعت گیری را در درمان سیاه سرفه دارند:
- قرص آزیترومایسین
- شربت اریترومایسین
- کلاریترومایسین
آنتیبیوتیکها با از بین بردن باکتری عامل بیماری، به بهبود سریع تر و افت زمان زمان انتقال بیماری پشتیبانی میکنند. برای درمان نیز پزشک میتواند داروهای فرد دیگر تجویز کند، چون آنتیبیوتیک تنها در از بین بردن باکتری و عفونت موثر است.
درمان خانگی سیاه سرفه
درمان خانگی سیاه سرفه زیاد تر با مراقبتهای ملزوم و منفعت گیری از راه حلهای طب سنتی انجام میبشود که شامل موارد زیر است:
- بیمار باید مقدار کافی آب در طول روز مصرف کند تا بدنش هیدراته بماند.
- تعداد قولهای غذایی روزانه باید افزایش و مقدار هر وعده افت اشکار کند.
- از مصرف سیگار و مواردی که میتوانند علتتحریک گلو و بدتر شدن سرفه شوند، پرهیز کنید.
در طب سنتی نیز منفعت گیری از برخی گیاهان و روغنهای گیاهی میتواند به افت علائم سیاه سرفه پشتیبانی کند:
- روغن اکالیپتوس؛ برای درمان علائم سرماخوردگی، سرفه و تجمع مخاط و التهاب دستگاه تنفسی فوقانی موثر است. میتوانید ۳ بار در روز بخور این روغن را منفعت گیری کنید.
- روغن نعنا فلفلی؛ بخور این روغن نیز برای افت علائم سرفه سودمند است.
- شیرینگفتن؛ غرغره این ماده یا مصرف آن به طور چای، میتواند به افت سرفه و پاکسازی مجری تنفسی پشتیبانی کند.
- چای سبز؛ خواص ضدباکتریایی این ماده میتواند به درمان عفونت سیاه سرفه پشتیبانی کند.
در کنار موارد بالا، پونه کوهی و لیمو، عسل، زنجبیل، روغن بادام، زردچوبه و غرغره آب نمک نیز میتواند علائم سرفه و گلودرد ناشی از سیاه سرفه را بهبود دهد. دقت داشته باشید که راه حلهای درمان خانگی سیاه سرفه، بهگفتن درمان قطعی این بیماری در نظر گرفته نمیشوند. درمان سیاه سرفه تنها با مراجعه به پزشک و مصرف داروهای موثر برای از بین بردن باکتری عامل عفونت مقدور است.

درمان سریع و مراقبتهای خانگی سیاه سرفه نوزادان
برای درمان سریع سیاه سرفه نوزادان باید به دکتر اطفال مراجعه کنید تا با مصرف دارو عفونت و علائم این بیماری بهبود اشکار کند. این بیماری در نوزادان خطرناک است و با مراجعه سریع به پزشک متخصص میتوان از خطرات بعدی آن تاحدزیادی جلوگیری کرد. پزشک متخصص میتواند از داروهای زیر برای درمان سیاه سرفه نوزادان منفعت گیری کند:
- نوزادان یکماهه؛ ماکرولیدها یا آنتیبیوتیکهای موثر در درمان عفونت باکتریایی
- در نوزادان ۲ ماهه و افراد با سن بالاتر؛ آنتیبیوتیکها و راه حلهای دیگر
دربرخیموارد، بهخصوص در نوزادان با علائم شدید، بستری شدن در بیمارستان برای دریافت اکسیژن و مراقبتهای اختصاصی الزامی است.
آیا با تزریق واکسن میتوان از سیاه سرفه پیشگیری کرد؟
تزریق واکسن سیاه سرفه یکی از موثرترین راه حلها برای پیشگیری از این بیماری است. واکسن سیاه سرفه به بدن پشتیبانی میکند تا آنتیبادیهایی تشکیل کند که با باکتری عامل این بیماری مبارزه میکنند. این واکسن طبق معمول با دیگر واکسنهای الزامی ترکیب و به افراد در سنین پایین تزریق میبشود. دوزهای یادآور این بیماری نیز در سنین بالاتر به ایمنی بیشتر در برابر سیاه سرفه پشتیبانی میکند. تزریق واکسن در گروههای پرخطر، افراد با سیستم ایمنی ضعیف و نوزادان اهمیت زیاد بالاتری دارد.
برای درمان سیاه سرفه به چه دکتری باید مراجعه کنیم؟
درمان سیاه سرفه با مراجعه به دکتر ریه و بازدید علائم و درصورتنیاز تجویز راه حلهای تشخیصی اغاز میبشود. علائم سیاه سرفه شامل سرفههای شدید و مکرر، تب، آبریزش بینی و کبود شدن صورت به زمان سرفه است. هماین چنین، امکان پذیر صدای جیغ یا سوتمانندی در زمان نفس کشیدن نیز تشکیل بشود. پزشک برای تشخیص سیاه سرفه میتواند از کشت باکتریایی، PCR و تست سرولوژی پشتیبانی بگیرد. دکتر سیاه سرفه باتوجه به حالت بیمار، آنتی بیوتیکهای موثر را برای از بین بردن عفونت سیاه سرفه تجویز میکند.
درضمن، برای ثبت نوبت بهترین فوقتخصص ریه یا دیگر تخصصهای مرتبط با درمان سیاه سرفه در شهر خودتان، میتوانید به پلتفرم آنلاین و سلامتی دکتردکتر مراجعه کنید.
منبع های:
cdc.gov
who.int
nhs.uk
سوالات متداول سیاه سرفه
به علت سرفههای شدید و مکرر که امکان پذیر به کبودی صورت منجر بشود، به این بیماری سیاه سرفه میگویند.
سیاه سرفه با مصرف آنتیبیوتیکها دراغلبموارد قابل درمان است، اما مراجعه سریع به پزشک اهمیت بسیاری دارد.
مراجعه سریع به پزشک، بستری شدن در بیمارستان و مراقبتهای اختصاصی به اختصاصی برای نوزادان، بهترین روش درمان است.
بله، سیاه سرفه به اختصاصی برای نوزادان و کودکان خردسال میتواند زیاد خطرناک و حتی کشنده باشد.
درصد ایمنی واکسن سیاه سرفه تا %۹۰ است که برای پیشگیری از این بیماری تاثییر زیاد بسیاری دارد. اما همانند هر واکسن فرد دیگر ایمنی کامل نیست و امکان پذیر افراد واکسینهشده نیز مبتلا شوند.
برچسبها:
دسته بندی مقالات
[ad_2]